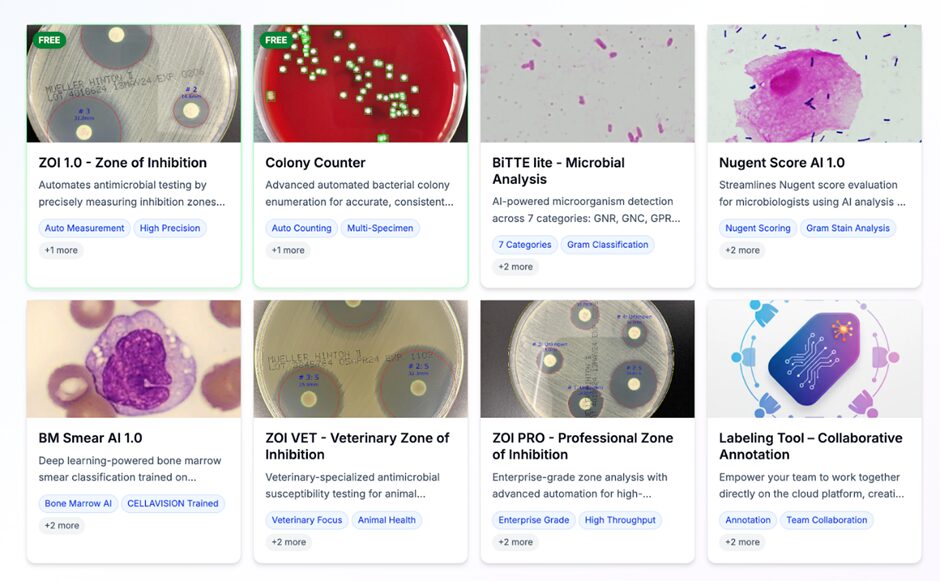

– Enabling Organization-Wide Digital and AI Transformation to Accelerate Adoption in the Life Sciences –
CarbGeM Inc. (Headquarters: Shibuya-ku, Tokyo; CEO: Masakazu Nakajima) today announced the official release of “CarbConnect® for Organizations,” a new enterprise platform of its cloud-based AI image analysis system CarbConnect®.
Previously available to individual researchers, the upgraded platform now supports organization ID management, access control, team collaboration, API integration, and secure cloud storage.
This enables hospitals, universities, research institutions, and enterprises to deploy AI in large-scale, multi-site environments—comprehensively supporting digital transformation in research and development.
▶ Service page: https://product.panel.carb-connect.com/

CarbConnect® was originally developed as a cloud platform for AI-powered image analysis across research, testing, and manufacturing in the life sciences field.
While adoption had been expanding primarily among individual researchers, the growing demand for team- and organization-level AI implementation has become increasingly evident.
Research workflows that relied heavily on manual or person-dependent operations now require systems that ensure both efficiency and security at scale.
To address these needs, CarbGeM has developed CarbConnect® for Organizations, a next-generation platform equipped with enterprise-grade security architecture and collaboration tools.
It serves as an integrated environment supporting the entire research and development process—from data analysis and sharing to AI model development and deployment.
CarbConnect® for Organizations is a cloud-based AI image analysis and data management platform designed specifically for hospitals, universities, research institutes, and life science companies.
Within a secure collaborative environment, users can centrally manage and operate multiple AI tools used in the life sciences, including inhibition zone measurement, Nugent score evaluation, blood cell classification, and Gram stain image analysis.
▶ Service page: https://product.panel.carb-connect.com/
The platform is offered as a cloud-based SaaS (monthly or annual subscription) with a 14-day free trial.For small teams and research groups, the Basic Plan starts at ¥30,000/month (tax included).
Different pricing plans are available for universities, clinical laboratories, and enterprise R&D environments.
Currently, the individual version of CarbConnect® has over 10,000 registered users across more than 10 countries, supporting AI adoption and data utilization across a wide range of research settings.
Going forward, CarbGeM will leverage CarbConnect® for Organizations as a foundation to accelerate DX and AI implementation across diverse life science domains, including food manufacturing, cell production, drug discovery, cosmetics, and industrial R&D.
The company also aims to establish a global AI ecosystem bridging medical, industrial, and researchfields through collaborations with international research institutions, CROs, and hospital networks.
CarbGeM Inc. integrates advanced AI and biotechnology to develop and deliver DX/AI solutions across the medical and life science fields. Through products such as AI-based research tools, imaging analysis platforms, and automated diagnostic systems, CarbGeM enhances efficiency in laboratories and healthcare settings while addressing global disparities in medical access.
Leveraging its proprietary AI infrastructure and digital platforms, the company supports collaboration among researchers and clinicians and contributes to solving global challenges such as antimicrobial resistance (AMR). CarbGeM has been recognized with multiple awards, including the Tokyo Social Innovation Tech Award 2024, and continues to drive open innovation with leading research institutions and industry partners.
Company Information
Company Name: CarbGeM Inc.
Representative: Masakazu Nakajima, CEO
Headquarters: 1-5-13 Jinnan, Shibuya-ku, Tokyo, Japan
Established: March 2021
Business Domain: Development and provision of AI and biotechnology-based solutions
Website: https://carbgem.com/en